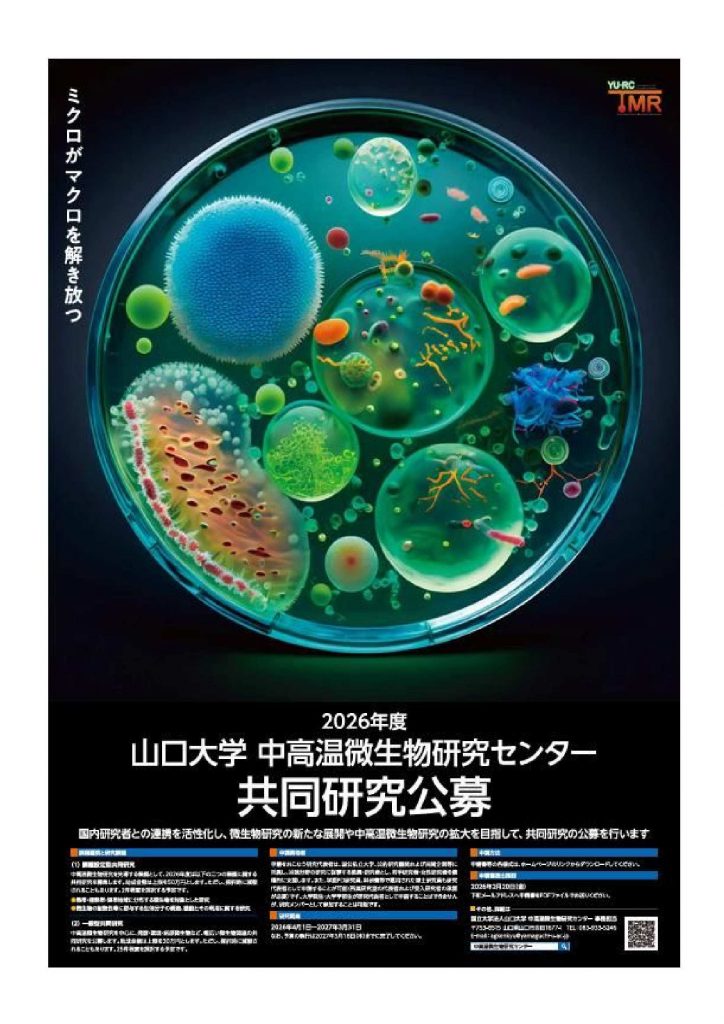

2026年度「共同研究」公募開始のお知らせ
以下の要領で、2026年度の共同研究を公募し、その共同研究に必要な旅費および研究費の支援を行います。
本センター所有の設備や、生物資源(遺伝子資源)を利用した共同研究を奨励しますので、これらの利用がある場合は申請書にその旨を明確に記載してください。
積極的なご応募をお待ちしております。
「2026年度公募型共同研究」募集詳細 ⇒

カテゴリー:
以下の要領で、2026年度の共同研究を公募し、その共同研究に必要な旅費および研究費の支援を行います。
本センター所有の設備や、生物資源(遺伝子資源)を利用した共同研究を奨励しますので、これらの利用がある場合は申請書にその旨を明確に記載してください。
積極的なご応募をお待ちしております。
カテゴリー: